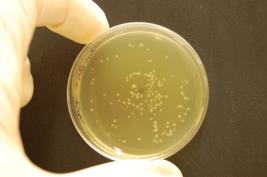
Ozon 3 * 24 Sek. (sofort)
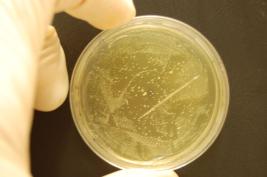
Ozon 1 * 24 Sek. (sofort)
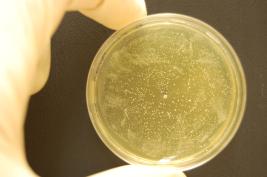
Ozon 3 * 24 Sek. (sofort)
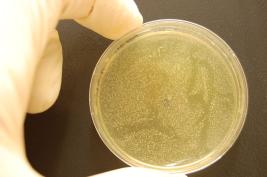
Ozon 3 * 24 Sek. (nach 1,5 h)
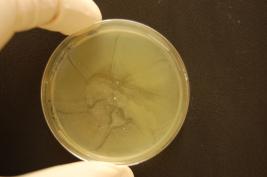
Ozon 1 * 24 Sek. (nach 1,5 h)

Inaktivierung von Bakterien mittels W&H Prozone
Die Wirkung von Prozone dem Ozon-Generator der Firma W&H wurde in einer Studie von Doz. Dr. Kristjan Plätzer, B. rer. nat. Corina Dallinger & Prof. Dr. Barbara Krammer, Abteilung für molekular Biologie der Universität Salzburg (Österreich), getestet. Die ersten Ergebnisse der Studie wurden bereits im März 2010 in der Dental Tribune veröffentlicht.
Studiendetails
Ziel
Ziel der Studie war es, die Wirksamkeit einer Ozonbehandlung mittels Prozone unter Verwendung der Endo-Spitze der Firma W&H zu überprüfen.
Studienaufbau
Die Effektivität wurde an zwei Modellorganismen, dem gram(+) Bakterium Streptococcus mutans und dem gram(-) Bakterium Escherichia coli als Repräsentanten der zwei Bakteriengruppen überprüft. Um die Fragestellung zu evaluieren wurde ein Experiment auf Agarschälchen (Durchmesser 6 cm) gestartet. Dabei wurde unterschieden zwischen einer sofortigen Behandlung ohne Einwachsen der Bakterien (gekennzeichnet mit „sofort“) und einer Behandlung nachdem die Bakterienzellen für 1,5 Stunden in das Medium einwachsen konnten (gekennzeichnet mit „nach 1,5 h“).
In allen Experimenten wurde die Effektivität von Ozon bei einer Begasungsdauer von 24, 3*24, 5*24 und 7*24 Sekunden überprüft. Die Kontrollproben wurden nicht begast.
Resultate
Die durchgeführten Experimente zeigen, dass bei sofortiger Begasung mit Ozon sichtbare Effekte nach 24 Sekunden Behandlungsdauer auftreten. Sowohl beim Bakterienstamm E.coli, wie auch S.mutans. Nach 1,5 stündigem Einwachsen sind die behandelten Felder durchwegs kleiner. Dennoch können Areale mit verringerter Keimzahl erzeugt werden. Mit zunehmender Behandlungdauer wird die Fläche, in der sich keine / wenige Keime befinden immer größer.
Behandlung von Agrarplatten mit dem bakterienstamm E. coli



Bei Begasungen mit mehr als 24 Sekunden sind größere bakterienfreie Flächen messbar, auf denen nur einzelne Bakterien zurückbleiben, die Kolonien bilden. Beispielhaft sei auch hier der Effekt bei einer 3*24sek. Begasungszeit dargestellt.

Behandlung von Agarplatten mit dem Bakterienstamm S. mutans

Bei Begasungen mit mehr als 24 Sekunden sind größere bakterienfreie Flächen messbar, auf denen nur einzelne Bakterien zurückbleiben, die Kolonien bilden. Beispielhaft sei hier der Effekt bei einer 3*24sek. Begasungszeit dargestellt.

Die Firma W&H empfiehlt im Allgemeinen die im Gerät integrierte Luftfilterkartusche nach rund 500 Anwendungen zu tauschen. Um die Wirksamkeit der Ozon Behandlung auch nach Ablauf dieser Frist zu überprüfen wurden zusätzliche Experimente durchgeführt.
Behandlung von Agarplatten mit dem Bakterienstamm E. coli
mit alter Luftfilterkartusche


Behandlung von Agarplatten mit dem Bakterienstamm S. mutans
mit alter Luftfilterkartusche

Auch bei der Verwendung alter Luftfilterkartuschen können bei einer Begasung von 24 Sekunden noch immer bakterienfreie Flächen gemessen werden. Dabei ist die sofortige Behandlung ohne Einwachsen der Bakterien (gekennzeichnet mit „sofort“) wiederum geringfügig wirksamer als eine Behandlung, die durchgeführt wurde, nachdem die Bakterienzellen für 1,5 Stunden in das Medium einwachsen konnten (gekennzeichnet mit „nach 1,5 h“).
Interpretation der Ergebnisse
Insgesamt ergibt die Behandlungszeit von 24 Sekunden bei allen Experimenten eine Fläche mit reduzierter Keimzahl. Aufgrund der punktuellen Anwendung in der Zahnmedizin und der durchschnittlichen Größe eines Molaren mit rund 5,8 mm, ist die antibakterizide Wirkung der 24 sekündlichen Behandlung innerhalb dieser Fläche als effektiv anzusehen. Als ganz wesentlich ist festzuhalten, dass der Zustand der Luft-Trocknerkartusche eine deutliche Auswirkung auf die antibakterielle Wirkung der Ozonbehandlung hat.
Kommentare